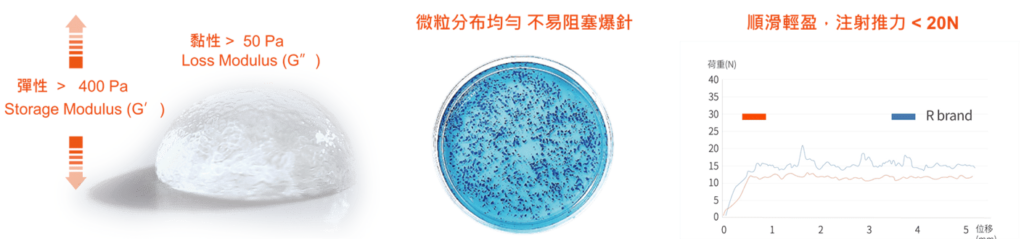

Introduce
療程介紹
⟡MIT台灣生技鉅作,專為東方人研發的醫美新選擇
 來自台灣醫療器材業領導品牌 MBI 和康生技,也是TCI 大江集團生技大聯盟成員之一,自 1998 年成立以來,專注於玻尿酸與膠原蛋白技術研發,產品涵蓋醫美、骨科、牙科等領域,並獲得歐盟 CE、 美國 FDA等多項國際認證,銷售遍及全球 22 國。
來自台灣醫療器材業領導品牌 MBI 和康生技,也是TCI 大江集團生技大聯盟成員之一,自 1998 年成立以來,專注於玻尿酸與膠原蛋白技術研發,產品涵蓋醫美、骨科、牙科等領域,並獲得歐盟 CE、 美國 FDA等多項國際認證,銷售遍及全球 22 國。
憑藉深厚的研發經驗,和康生技運用獨家玻尿酸交聯技術,推出專為亞洲人打造的「氧氣玻尿酸」,以安全、長效、高 CP 值的優勢,掀起台灣醫美微整市場的新革命,讓MIT 台灣製造的卓越品質享譽國際!

⟡氧氣玻尿酸「長效×安心」雙重關鍵
 玻尿酸填充療程是微整入門首選,但要達到自然持久的效果,除了醫師技術,玻尿酸本身的穩定性與安全性至關重要。
玻尿酸填充療程是微整入門首選,但要達到自然持久的效果,除了醫師技術,玻尿酸本身的穩定性與安全性至關重要。
💎 絲登齡 MissStunnin® 氧氣玻尿酸(衛部醫器製字第007549號 / 仿單名稱:絲登齡皮膚填補劑)
💎 依據亞洲輪廓、膚質與消費者習性設計,全面滿足台灣市場需求
💎 具備長效支撐力與極致安全性,同時擁有高 CP 值

1.長效關鍵:ECHA™ 專利交聯技術
未交聯玻尿酸的分子結構鬆散,易被人體快速代謝,導致效果不持久。
氧氣玻尿酸獨家 ECHA™ 專利交聯技術
✔ 均勻交聯分子,提升玻尿酸結構穩定性
✔ 玻尿酸鏈解優化,提高凝聚力與支撐效果
✔ 長時間溫控發酵工藝,增加黏彈性與持久度
💡效果更持久,支撐力更穩定,延長玻尿酸在體內的作用時間!
2.安心關鍵:BDDE 殘留趨近於零
玻尿酸交聯過程中常需使用 BDDE 交聯劑,但殘留過高恐增加過敏與發炎風險。
氧氣玻尿酸 BDDE 殘留 < 0.125 ppm(遠低於國際標準 2 ppm)
✔ 最少量 BDDE 交聯劑,高效率交聯比例
✔ WASH 純化技術,徹底去除雜質
✔ 降低過敏、發炎等副作用,提升組織相容性
💡穩定玻尿酸結構的同時,確保安全性,讓消費者安心選擇!

⟡氧氣玻尿酸4大優勢
1/安全親膚
✔ 美國 FDA 認證原料,高純度透明質酸鈉
✔ 低過敏、低毒性,與人體組織相容性高
✔ 臨床證實安全性與有效性兼具


2/穩定持久
✔ ECHA™ 交聯技術,增強玻尿酸內聚力
✔ 減緩人體代謝,延長維持時間
✔ 抗酵素降解能力媲美國際知名品牌


3/輕盈柔塑
✔ 微粒均勻,施打更順暢,減少異物感
✔ 高度延展性,適合五官雕塑與填補凹陷
✔ 不易位移,效果更穩定
4/ 高CP值
✔ 效果媲美歐美進口玻尿酸
✔ 親民價格,減少重複施打成本
✔ 經濟實惠又持久,是愛美族群的最佳選擇!

⟡氧氣玻尿酸劑型
 氧氣玻尿酸擁有3種不同的劑型,可依支撐度及適用層次靈活搭配,並根據個人需求、施打部位由醫師評估適合方案。
氧氣玻尿酸擁有3種不同的劑型,可依支撐度及適用層次靈活搭配,並根據個人需求、施打部位由醫師評估適合方案。
🔹Luminous 絲登齡®亮妍 — 中分子,適合用於豐唇、改善淚溝眼周區域,或是臉部表淺皺紋。
🔹Prevalent 絲登齡®丰妍 — 大分子,適合用於蘋果肌、頰凹、太陽穴等廣泛範圍。
🔹Fathomless 絲登齡®煥妍 — 特大分子,適用於法令、豐額、隆鼻、下巴等深層填補及立體塑型。
| 產品型號 | Luminous 亮妍 | Prevalent 丰妍 | Fathomless 煥妍 |
| 產品外觀 |  |  |  |
| 粒徑大小 | 中分子350-500 μm | 大分子700-900 μm | 特大分子1000-2000 μm |
| 黏彈性質 | 400-500G’50-150 G” Pa | 500-600G’50-150 G” Pa | 800-900G’50-150 G” Pa |
| 濃度比例 | 20 mg/mL | ||
| BDDE | < 0.125 ppm | ||
| 注射層次 |  |  |  |
| 適合部位 | 眼周、唇部、淺層溝痕 | 豐盈雙頰、太陽穴、深層凹陷 | 法令、鼻部、下巴等輪廓塑型 |
| 搭配注射器 | 27G X 1/2” / 30G X 1/2” | 27G X 1/2” | 25G X 1/2” |
NOTICE
注意事項
- 嚴重精神異常、嚴重過敏或有蟹足腫(Keloid)等疤痕增生體質者、心理障礙、心血管等重要臟器疾病、全身性或注射部位感染、使用抗凝血藥物等患者須經由醫師謹慎評估。
- 如果您正在服用藥物,懷孕或授乳中,應如實告訴醫生,以便醫生判斷。
- 施打部位曾動過手術、放置假體,或近一個月曾使用晶亮瓷(微晶瓷)、玻尿酸、水微晶、人工真皮或膠原蛋白…等填充物治療之患者應事先告知醫師。
- 未滿 18 歲或無行為能力的就醫者應由其監護人陪同就醫和簽字。
- 正在服用人蔘、魚油、銀杏、止痛藥、阿司匹林、維他命E或其他促進血液循環、降低血液凝固機能的食品藥品者,瘀青機率稍高,但仍可施打。
- 微整填充物治療後並不會影響生活作息,但仍需注意療程後禁止壓迫該治療部位,例如:鼻樑山根處,一周內避免配戴眼鏡、太陽眼鏡、過緊的口罩等,如下巴、蘋果肌處,則一周內避免壓迫該療程處。
- 注射當日避免接觸患部、按摩注射的部位,可用輕柔的動作配合室溫溫度以下的冷水清潔、忌飲酒。
- 注射完24小時內避免做劇烈運動以及游泳。
- 注射完72小時內避免前往三溫暖、烤箱、蒸氣間、溫泉、桑拿等高溫場所。
- 服用阿司匹林或其他類似抗凝血藥物者可能會增加青腫及流血機率,進而影響傷口愈合速度。
- 術後可於施打部位多進行濕敷或者加強保濕產品護理。
FAQ
常見問題
氧氣玻尿酸填入後可立即看見改善效果,約1個月後玻尿酸與肌膚組織緊密貼合,整體效果也會更加自然。一般來說,玻尿酸效果約維持6個月至1年左右,並因每個人的生活型態與體質等因素影響而有所差異。
禾伊美學所使用的產品皆經過TFDA認證,可被人體吸收代謝,不會累積在體內導致硬化、癌變等風險,因此非常安全。
但人體臉部分佈著密集的血管和神經,若填充劑誤入血管可能導致血管栓塞,造成軟組織壞死、失明甚至死亡等嚴重併發症,因此選擇合格且經驗豐富的醫師非常重要。
此外,部份不良醫美診所,為求打出低價號召客戶,而使用來歷不明的雜牌劣質產品,或是使用稀釋過後的產品,以降低成本,但這些品質堪慮的產品會大大影響療效時間與療程效果,提醒您保護自身權益。
氧氣玻尿酸價格依單位數計算,相對於目前市面上的玻尿酸填充劑而言,屬於經濟實惠、CP值高的產品,不僅適用於精打細算的小資族,也是替換國際一線品牌的絕佳選擇。
抗老療程通常不以年齡為基準,而是以老化程度為治療計畫的關鍵點,但我們每個人的流失老化狀況與審美標準都不一樣,因此只要超過18歲的法定年齡,以及本身健康無虞、不具禁忌症與特殊體質,基本上玻尿酸療程沒有特定的限制。
